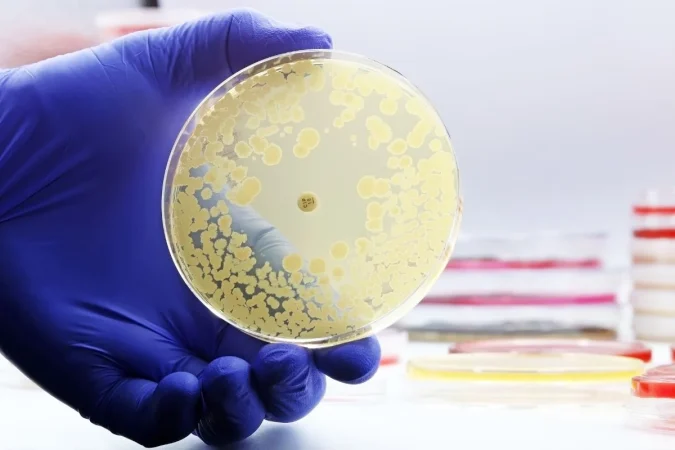
antibiotico

La resistencia a los antibióticos suena lejana, casi abstracta, hasta que te das cuenta de que no es un problema del futuro, sino del presente. Los expertos la llaman pandemia silenciosa porque no llena titulares diarios, pero avanza sin hacer ruido, como una gotera constante que acaba debilitando toda la estructura.
En esencia, ocurre cuando las bacterias aprenden a esquivar los medicamentos creados para eliminarlas. Se adaptan, resisten y sobreviven. Y con cada intento fallido, la medicina moderna pierde un poco de terreno. No hablamos de ciencia ficción: hablamos de infecciones que ya no responden, de tratamientos que antes funcionaban y ahora no.
Entender cómo hemos llegado hasta aquí es el primer paso para no seguir cavando el hoyo.
Bacterias: compañeras invisibles… hasta que dejan de serlo
Conviene aclararlo desde el principio: no todas las bacterias son malas. De hecho, la mayoría viven con nosotros en una especie de pacto silencioso. Nos ayudan a digerir, a producir vitaminas, a entrenar al sistema inmune. Sin ellas, estaríamos perdidos.
El problema aparece cuando unas pocas —muy pocas— se vuelven resistentes. Y ahí el equilibrio se rompe. Como explica José Moreno, esto es darwinismo en estado puro: presionas a una bacteria con un antibiótico y, si sobrevive, sale reforzada. El abuso y el mal uso de estos fármacos hacen justo eso: seleccionar a las más fuertes, las que ya no temen a nada.
Y claro, luego nos sorprendemos cuando el tratamiento deja de funcionar.
Cómo se organizan las bacterias para sobrevivir

Aquí viene una de las partes más inquietantes. Las bacterias no solo evolucionan; se comunican, aprenden y comparten información. Algunas utilizan virus como mensajeros genéticos, otras incorporan fragmentos de ADN de bacterias muertas (sí, literalmente “aprenden” de las caídas ajenas).
También actúan en grupo. Mediante un sistema de comunicación llamado quorum sensing, deciden cuándo atacar, cuándo resistir y cuándo compartir recursos. Moreno lo resume con ironía: “Las bacterias se ponen de acuerdo; los humanos no siempre”.
A veces incluso liberan pequeñas cápsulas cargadas de información genética resistente, como si dejaran mensajes en botellas para que otras las recojan. Todo muy sofisticado. Demasiado.
Cuando los antibióticos dejan de protegernos

La pérdida de eficacia de los antibióticos no se limita a infecciones comunes. Amenaza los pilares de la medicina moderna. Cirugías, trasplantes, prótesis… casi todo depende de que estos fármacos sigan funcionando. Sin ellos, volveríamos a un escenario parecido al del siglo XIX, cuando una herida tonta podía acabar en tragedia.
En lugares como Panamá, esta amenaza se intensifica. Su posición estratégica y el constante movimiento de personas facilitan la llegada de bacterias altamente resistentes. Algunas, como Acinetobacter baumannii, presentan niveles de resistencia superiores al 80 %. A su lado, nombres como Klebsiella, Pseudomonas o Staphylococcus aureus ya no suenan tan lejanos en los hospitales.
Una sola salud y una responsabilidad compartida
Este problema no se queda entre las paredes de un hospital. La salud humana, animal y ambiental están conectadas, queramos o no. El uso masivo de antibióticos en ganadería, acuicultura y agricultura libera residuos que acaban en el entorno… y vuelven a nosotros. Frutas tratadas, peces medicados, ganado sobreexpuesto. Todo suma.
¿Qué podemos hacer? Para empezar, no automedicarnos. Tomar antibióticos para un virus no solo no sirve, debilita nuestra microbiota. Cuidar el sistema inmunitario con hábitos básicos —comer mejor, moverse más— también cuenta. Y, por supuesto, hacen falta leyes valientes que frenen el abuso a gran escala.
La idea final es sencilla, aunque incómoda: los antibióticos no son infinitos. Cuidarlos hoy es la única manera de asegurarnos de que sigan ahí cuando realmente los necesitemos. Porque perderlos no sería solo un retroceso médico. Sería un fracaso colectivo.






